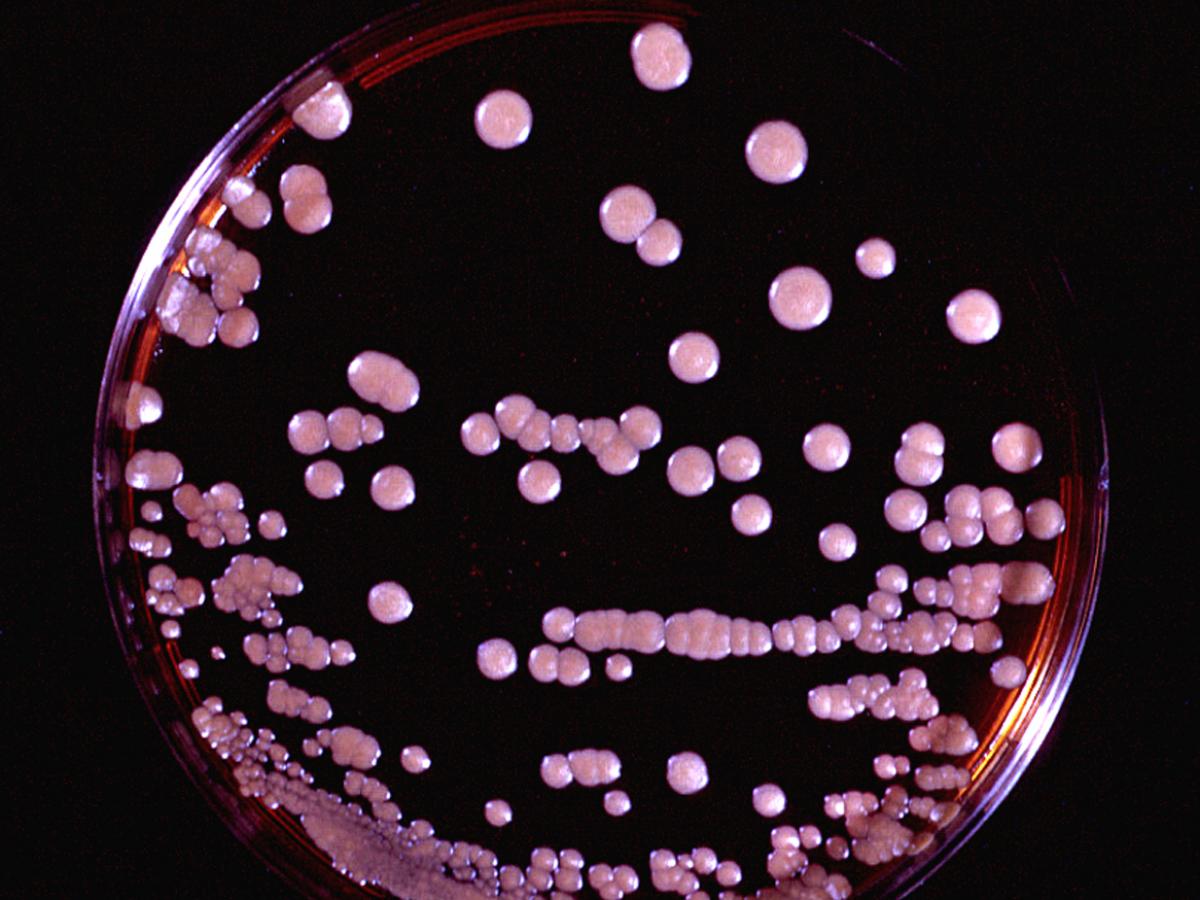
Malassezia culture

Superficial Mycoses
These are superficial cosmetic fungal infections of the skin or hair shaft.
No living tissue is invaded and there is no cellular response from the host. Essentially no pathological changes are elicited. These infections are often so innocuous that patients are often unaware of their condition.
| Disease | Causative organisms | Incidence |
|---|---|---|
| Pityriasis versicolor Seborrhoeic dermatitis including Dandruff and Follicular pityriasis |
Malassezia spp. (a lipophilic yeast) |
Common |
| Tinea nigra | Hortaea werneckii | Rare |
| White piedra | Trichosporon spp. | Common |
| Black piedra | Piedraia hortae | Rare |
Mycoses descriptions
-
Malassezia infections
Malassezia species are basidiomycetous yeasts and form part of the normal skin flora of humans and animals. The genus now includes 14 species of which 13 are lipid dependent. These include M. caprae (goat, horse), M. cuniculi (rabbit), M. dermatis (human), M. equina (horse, cow), M. furfur (human, cow, elephant, pig, monkey, ostrich, pelican), M. globosa (human, cheetah, cow), M. japonica (human), M. nana (cat, cow, dog), M. obtusa (human), M. pachydermatis (dog, cat, carnivores, birds), M. restricta (human), M. slooffiae (human, pig, goat, sheep), M. sympodialis (human, horse, pig sheep) and M. yamatoensis (human) (Cabanes et al. 2011).
M. sympodialis, M. globosa, M. slooffiae and M. restricta are the most frequently found species responsible for colonisation of humans (Arendrup et al. 2014).
Malassezia species may cause various skin manifestations including pityriasis versicolor, seborrhoeic dermatitis, dandruff, atopic eczema and folliculitis. M. pachydermatis is known to cause external otitis in dogs. Fungaemia due to lipid-dependent Malassezia species usually occurs in patients with central line catheters receiving lipid replacement therapy, especially in infants (Tragiannides et al. 2010, Gaitanis et al. 2012, Arendrup et al. 2014).
Note:
With the exception of M. pachydermatis, the primary isolation and culture of Malassezia species is challenging because in vitro growth must be stimulated by natural oils or other fatty substances. The most common method used is to overlay Sabouraud’s dextrose agar (SDA) containing cycloheximide (actidione) with olive oil or alternatively to use a more specialised media like modified Leeming and Notham agar (Kaneko et al. 2007), or modified Dixon’s agar (see specialised culture media).Clinical manifestations

Pityriasis versicolor showing hyperpigmented lesions.
Pityriasis versicolor:
This is a chronic, superficial fungal disease of the skin characterised by well-demarcated white, pink, fawn, or brownish lesions, often coalescing, and covered with thin furfuraceous scales. The colour varies according to the normal pigmentation of the patient, exposure of the area to sunlight, and the severity of the disease. Lesions occur on the trunk, shoulders and arms, rarely on the neck and face, and fluoresce a pale greenish colour under Wood's ultra-violet light. Young adults are affected most often, but the disease may occur in childhood and old age.
Pityriasis versicolor showing hyperpigmented lesions.
Pityriasis folliculitis:
This is characterised by follicular papules and pustules localised to the back, chest and upper arms, sometimes the neck, and more seldom the face. These are itchy and often appear after sun exposure. Scrapings or biopsy specimens show numerous yeasts occluding the mouths of the infected follicules. Most cases respond well to topical imidazole treatment, however patients with extensive lesions often require oral treatment with ketoconazole or itraconazole. Once again, prophylactic treatment once or twice a week is mandatory to prevent relapse.
Pityriasis folliculitis.
Seborrhoeic dermatitis and dandruff:
Current evidence suggests Malassezia, combined with multifactorial host factors is also the direct cause of seborrhoeic dermatitis, with dandruff being the mildest manifestation. Host factors include genetic predisposition, an emotional component (possible endocrine or neurologically mediated factors), changes in quantity and composition of sebum (increase in wax esters and a shift from triglycerides to shorter fatty acid chains), increase in alkalinity of skin (due to eccrine sweating) and external local factors such as occlusion. Patients with neurological diseases such as Parkinson's disease and those with AIDS are commonly affected. Clinical manifestations are characterised by erythema and scaling in areas with a rich supply of sebaceous glands ie the scalp, face, eyebrows, ears and upper trunk. Lesions are red and covered with greasy scales and itching is common in the scalp. The clinical features are typical and skin scrapings for a laboratory diagnosis are unnecessary. Once again, the use of a topical imidazole is recommended, especially ketoconazole which has proved to be the most effective agent. Relapse is common and retreatment when necessary is the simplest approach for long term management.Fungaemia:
Malassezia has also been reported as causing catheter acquired fungaemia in neonate and adult patients undergoing lipid replacement therapy. Such patients may also develop small embolic lesions in the lungs or other organs. Diagnosis requires special culture media and blood drawn back through the catheter is the preferred specimen. Culture of the catheter tip is also recommended.Laboratory diagnosis:
Clinical material:
Skin scrapings from patients with superficial lesions, blood and indwelling catheter tips from patients with suspected fungaemia.
GMS stained skin biopsy showing characteristic spherical yeast cells and short pseudohyphal elements typical of M. furfur; and 10% KOH with Parker ink mount showing characteristic spherical yeast cells and short pseudohyphal elements typical of the fungus.
Direct microscopy:
Skin scrapings taken from patients with Pityriasis versicolor stain rapidly when mounted in 10% KOH, glycerol and Parker ink solution and show characteristic clusters of thick-walled round, budding yeast-like cells and short angular hyphal forms up to 8um in diameter (ave. 4um diam.). These microscopic features are diagnostic for Malassezia furfur and culture preparations are usually not necessary.
Culture of M. furfur on Dixon's agar.
Culture:
Culture is only necessary in cases of suspected fumgaemia. M. furfur is a lipophilic yeast, therefore in vitro growth must be stimulated by natural oils or other fatty substances. The most common method used is to overlay Sabouraud's dextrose agar containing cycloheximide (actidione) with olive oil or alternatively to use a more specialized media like Dixon's agar which contains glycerol mono-oleate (a suitable substrate for growth).Serology:
There are currently no commercially available serological procedures for the diagnosis of Malassezia infections.Identification:
Microscopic evidence of unipolar, broad base budding yeast cells and special lipid requirements for growth in culture are usually diagnostic.Management:
The most appropriate antifungal treatment for pityriasis versicolor is to use a topical imidazole in a solution or lathering preparation. Ketoconazole shampoo has proven to be very effective. Alternative treatments include zinc pyrithione shampoo or selenium sulfide lotion applied daily for 10-14 days or the use of propylene glycol 50% in water twice daily for 14 days. In severe cases with extensive lesions, or in cases with lesions resistant to topical treatment or in cases of frequent relapse oral therapy with itraconazole [200 mg/day for 5-7 days] is usually effective. Mycologically, yeast cells may still be seen in skin scrapings for up to 30 days following treatment, thus patients should be monitored on clinical grounds. Patients also need to be warned that it may take many months for their skin pigmentation to return to normal, even after the infection has been successfully treated. Relapse is a regular occurrence and prophylactic treatment with a topical agent once or twice a week is often necessary to avoid recurrence.Further reading:
Ajello L and R.J. Hay. 1997. Medical Mycology Vol 4 Topley & Wilson's Microbiology and Infectious Infections. 9th Edition, Arnold London.
Elewski BE. 1992. Cutaneous fungal infections. Topics in dermatology. Igaku-Shoin, New York and Tokyo.
Kwon-Chung KJ and JE Bennett 1992. Medical Mycology Lea & Febiger.
Richardson MD and DW Warnock. 1993. Fungal Infection: Diagnosis and Management. Blackwell Scientific Publications, London -
Tinea nigra
A superficial fungal infection of skin characterised by brown to black macules which usually occur on the palmar aspects of hands and occasionally the plantar and other surfaces of the skin. World-wide distribution, but more common in tropical regions of Central and South America, Africa, South-East Asia and Australia. The aetiological agent is Hortaea werneckii a common saprophytic fungus believed to occur in soil, compost, humus and on wood in humid tropical and sub-tropical regions.

Typical brown to black, non-scaling macules on the palmar aspect of the hands. Note: there is no inflammatory reaction.
Clinical manifestations:
Skin lesions are characterised by brown to black macules which usually occur on the palmar aspects of hands and occasionally the plantar and other surfaces of the skin. Lesions are non-inflammatory and non-scaling. Familial spread of infection has also been reported.
Note:
There is no inflammatory reaction.
Skin scrapings mounted in 10% KOH showing pigmented brown to dark olivaceous (dematiaceous) septate hyphal elements and 2-celled yeast cells producing annelloconidia typical of Hortaea werneckii.
Laboratory diagnosis:
Clinical material:
Skin scrapings.Direct microscopy:
Skin scrapings should be examined using 10% KOH and Parker ink or calcofluor white mounts.Culture:
Clinical specimens should be inoculated onto primary isolation media, like Sabouraud's dextrose agar.
Colony and conidia of Hortaea werneckii.
Serology:
Not required for diagnosis.Identification:
Characteristic clinical, microscopic and culture features.Causative agents:
Hortaea werneckiiManagement:
Usually, topical treatment with Whitfield's ointment (benzoic acid compound) or an imidazole agent twice a day for 3-4 weeks is effective.Further reading:
Ajello L and R.J. Hay. 1997. Medical Mycology Vol 4 Topley & Wilson's Microbiology and Infectious Infections. 9th Edition, Arnold London.
Elewski BE. 1992. Cutaneous fungal infections. Topics in dermatology. Igaku-Shoin, New York and Tokyo.
Kwon-Chung KJ and JE Bennett 1992. Medical Mycology Lea & Febiger.
Richardson MD and DW Warnock. 1993. Fungal Infection: Diagnosis and Management. Blackwell Scientific Publications, London.
Rippon JW. 1988. Medical Mycology WB Saunders Co. -
White piedra
White piedra is a superficial cosmetic fungal infection of the hair shaft caused by Trichosporon. Infected hairs develop soft greyish-white nodules along the shaft. Essentially no pathological changes are elicited. White piedra is found worldwide, but is most common in tropical or subtropical regions.
Trichosporon species are a minor component of normal skin flora, and are widely distributed in nature. They are regularly associated with the soft nodules of white piedra, and have been involved in a variety of opportunistic infections in the immunosuppressed patient. Disseminated infections are most frequently (75%) caused by T. asahii (Arendrup et al. 2014) and have been associated with leukaemia, organ transplantation, multiple myeloma, aplastic anaemia, lymphoma, solid tumours and AIDS. Disseminated infections are often fulminate and widespread, with lesions occurring in the liver, spleen, lungs and gastrointestinal tract. Infections in non-immunosuppressed patients include endophthalmitis after surgical extraction of cataracts, endocarditis usually following insertion of prosthetic cardiac valves, peritonitis in patients on continuous ambulatory peritoneal dialysis (CAPD), and intravenous drug abuse.

White piedra showing soft, light brown nodules, adhering to the hairs.
Clinical manifestations:
Infections are usually localised to the axilla or scalp but may also be seen on facial hairs and sometimes pubic hair. White piedra is common in young adults. The presence of irregular, soft, white or light brown nodules, 1.0-1.5 mm in length, firmly adhering to the hairs is characteristic of white piedra.

KOH and Parker ink mount of a hair nodules of white piedra showing yeast-like cells of Trichosporon spp.
Laboratory diagnosis:
Clinical material:
Epilated hairs with white soft nodules present on the shaft.Direct microscopy:
Hairs should be examined using 10% KOH and Parker ink or calcofluor white mounts. Look for irregular, soft, white or light brown nodules, 1.0-1.5 mm in length, firmly adhering to the hairs.
Culture of hairs showing growth of Trichosporon app. typical of white piedra (photo courtesy of Prof. Gustavo Gini, Universidad Galileo, Guatemala City).
Culture:
Hair fragments should be implanted onto primary isolation media, like Sabouraud's dextrose agar. Colonies of Trichosporon spp. are white or yellowish to deep cream colored, smooth, wrinkled, velvety, dull colonies with a mycelial fringe.Serology:
Not required for diagnosis.Identification:
Characteristic clinical, microscopic and culture features.Causative agents:
The taxonomy of Trichosporon has been redefined: Trichosporon cutaneum, T. dermatis, T. jirovecii and T. mucoides have now been transferred to the new genus Cutaneotrichosporon, while Trichosporon domesticum, T. loubieri and T. mycotoxinovorans have now been included into the re-defined genus Apiotrichum (Liu et al. 2015).
Four species Trichosporon asahii, T. asteroides, T. inkin, and T. ovoides are the most common clinical isolates, however, T. cormiiforme, T. dohaense ,T. faecale, T. japonicum and T. lactis have also been reported from human and animal infections (Guarro et al. 1999; Rodriguez-Tudela et al. 2005, Chagas-Neto et al. 2008). Importantly, all speciesare resistant to echinocandins (Arendrup et al. 2014).
Management:
Shaving the hairs is the simplest method of treatment. Topical application of an imidazole agent may be used to prevent reinfection.Further reading:
Ajello L and R.J. Hay. 1997. Medical Mycology Vol 4 Topley & Wilson's Microbiology and Infectious Infections. 9th Edition, Arnold London.
Kwon-Chung KJ and JE Bennett 1992. Medical Mycology Lea & Febiger.
Rippon JW. 1988. Medical Mycology WB Saunders Co. -
Black piedra
Black piedra is a superficial fungal infection of the hair shaft caused by Piedra hortae, an ascomycetous fungus forming hard black nodules on the shafts of the scalp, beard, moustache and pubic hair. It is common in Central and South America and South-East Asia.
Clinical manifestations:
Infections are usually localised to the scalp but may also be seen on hairs of the beard, moustache and pubic hair. Black piedra mostly affects young adults and epidemics in families have been reported following the sharing of combs and hairbrushes. Infected hairs generally have a number of hard black nodules on the shaft. Black piedra may be confused with trichorrhexis nodosa and trichonodosis but mycological examination will always confirm the diagnosis.
Laboratory diagnosis:
Clinical material:
Epilated hairs with hard black nodules present on the shaft.Direct microscopy:
Hairs should be examined using 10% KOH and Parker ink or calcofluor white. Look for darkly pigmented nodules that may partially or completely surround the hair shaft. Nodules are made up of a mass of pigmented with a stroma-like centre containing asci.Culture:
Hair fragments should be implanted onto primary isolation media, like Sabouraud's dextrose agar. Colonies of Piedra hortae are dark, brown-black and take about 2-3 weeks to appear.Serology:
Not required for diagnosis.Identification:
Characteristic clinical, microscopic and culture features.Causative agents:
Piedra hortaeManagement:
The usual treatment is to shave or cut the hairs short, but this is often not considered acceptable, particularly by women. In-vitro susceptibility tests have shown that Piedra hortae is sensitive to terbinafine and it has been successfully used, at a dose of 250 mg a day for 6 weeks, to treat a 23 year old Swedish Caucasian man following a 4 month visit to India (Gip, 1994).Further reading:
Gip L, Black piedra: the first case treated with terbinafine. Br J Dermatol (1994) 130(Suppl.43):26-28.
Kwon-Chung KJ and JE Bennett 1992. Medical Mycology Lea & Febiger.
Richardson MD and DW Warnock. 1993. Fungal Infection: Diagnosis and Management. Blackwell Scientific Publications, London.
Rippon JW. 1988. Medical Mycology WB Saunders Co.